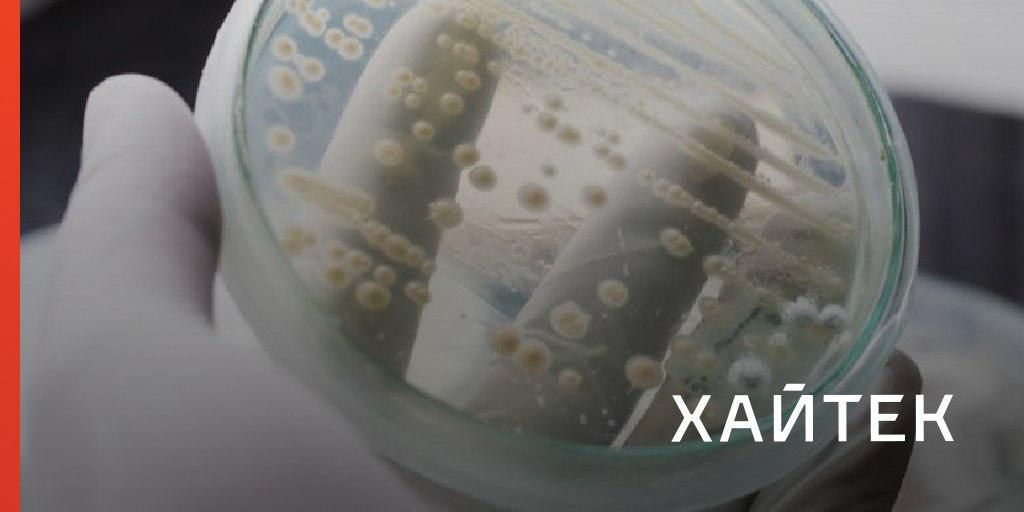

22 июля Индия запустила одноразовую ракету-носитель с межпланетной лунной станцией «Чандраян-2». Цель миссии — достичь орбиты Луны и совершить мягкую посадку на малоизученный южный полюс спутника.
Добираться до цели станция будет больше месяца — посадка намечена на 6 или 7 сентября. Если все пройдет успешно, то Индия станет четвертой державой после СССР, США и Китая, которой удалось осуществить мягкую посадку космического аппарата на спутник Земли.
Что будет изучать «Чандраян-2», зачем Индии собственная лунная миссия, как она будет проходить и почему аппарат так долго добирается до Луны — читайте в статье:
https://hightech.fm/2019/07/24/india-moon?io_source=tg